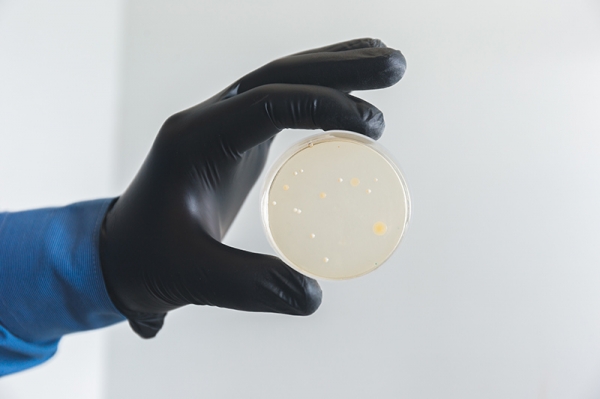
В Институте перспективных материалов и технологий создали самоочищающийся пластик
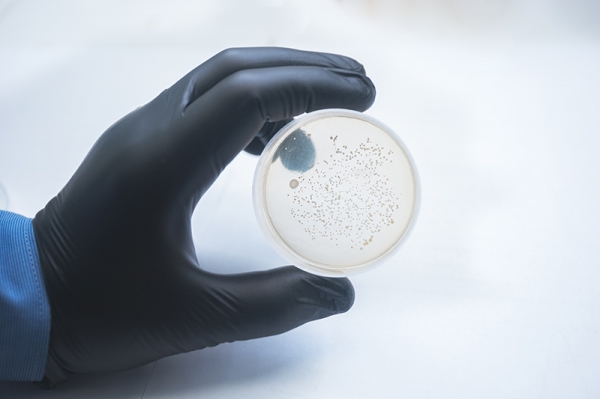
В Институте перспективных материалов и технологий создали самоочищающийся пластик

В ходе работы он взял два образца пластика – обычный абс-пластик и модифицированный нанонитями диоксида титана (~1 масс.%), и засеял поверхность обоих образцов колониями стафилококка – бактерии, которые встречается на руках человека и могут вызвать ряд опасных заболеваний.
Оба образца были на сутки помещены в термостат для размножения колоний, после чего был проведен смыв с поверхности образцов, который впоследствии помещался в специальную питательную среду для стафилококка – стафилококк-агар.
В питательной среде, также в инкубационных условиях, колонии находились еще двое суток.
В результате сравнения полученных образцов было выявлено, что на чистом пластике образовалось порядка 600 колониеобразующих единиц (КОЕ), а у модифицированного пластика – около 7 КОЕ.
Таким образом было продемонстрировано, что добавление нанонитей диоксида титана в абс-пластик повышает его антибактериальные свойства.
«Мы выяснили, что нанонити диоксида титана наделяют пластик способностью к самоочищению, – поясняет Андрей Тарасов. – На таком пластике стафилококк, а может быть и другие бактерии, не имеет возможности для активного размножения».
Колонии стафилоккокка, выращенные на модифицированном пластике (слева) и на не модифицированном пластике (справа)
В Институте ПМТ считают, что результаты эксперимента могут заинтересовать компании, которые создают оборудование или фурнитуру для больниц, инвентарь для общественного транспорта.
«Из пластика, модифицированного нанонитями диоксида титана можно делать дверные ручки, выключатели, или другие предметы, с которыми контактирует человек», – предположили в Институте ПМТ. – На сегодняшний день исследование и разработка способов модифицирования пластиков с антибактериальным эффектом или наделением их другими свойствами является перспективным направлением для дальнейших исследований».
- Ещё больше материалов и фотографий на: https://t.me/zelenogradinfo
- БЕCПЛАТНАЯ доска объявлений: https://зеленоград-инфо.рф/ads
- Группа VK: https://vk.com/zelekinfo